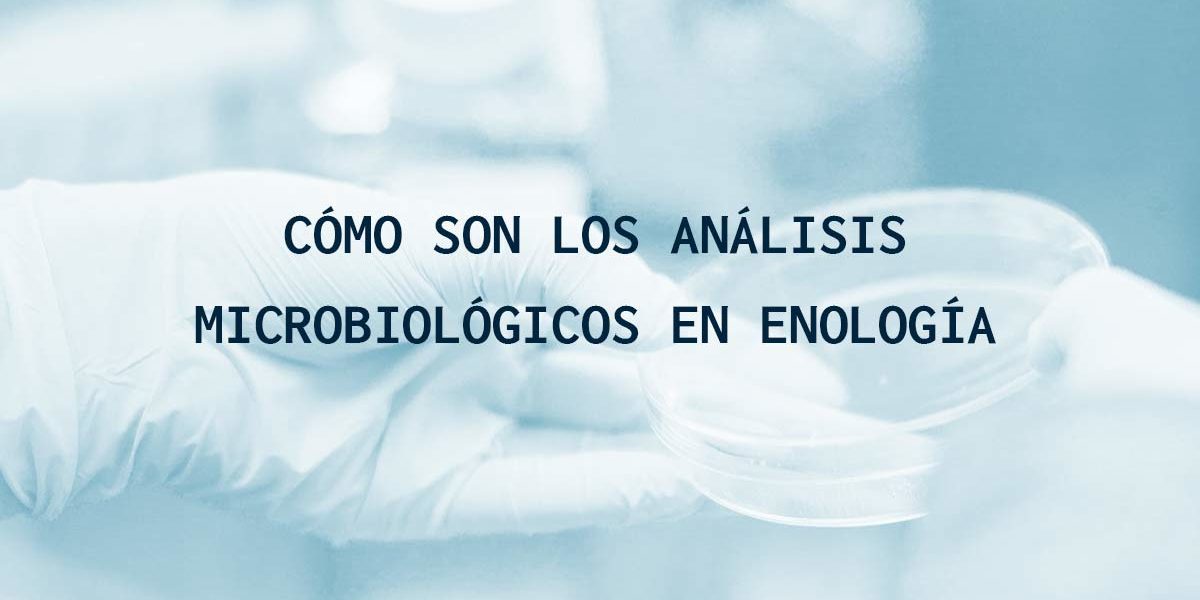
Cómo son los análisis microbiológicos en enología Cómo son los análisis microbiológicos en enología

La importancia del análisis microbiológico en el proceso de elaboración del vino y sus derivados reside en la necesidad de controlar las poblaciones microbianas que se encargan de transformar el mosto en vino, pero también aquellas que pueden provocar alteraciones en el mismo en etapas posteriores.
Proceso de elaboración del vino: fermentación
En el caso de la fermentación, estos microorganismos son esenciales para el desarrollo del mosto a vino, pero en etapas siguientes algunas poblaciones microbianas pueden instalarse en el producto y desarrollarse dando lugar a alteraciones y/o enfermedades.
Por ejemplo, cuando el mosto inicia su camino para transformarse en vino, es fundamental el desarrollo de levaduras para llevar a cabo la fermentación alcohólica, y posteriormente de bacterias lácticas, que se encargan de la fermentación maloláctica en los casos en que esta se lleve a cabo.
En esta primera etapa, resulta fundamental controlar la población y el tipo de levaduras que deseamos que desarrollen el proceso de fermentación en nuestro vino. Este estudio se vuelve imprescindible en la fase temprana de la elaboración del vino, donde el número de levaduras debe ser grande para metabolizar rápidamente los azúcares del mosto y producir etanol, pero también para detectar levaduras o mohos indeseados que pueden proliferar y llevar a cabo una fermentación inadecuada en nuestro producto, o afectar al desarrollo de la población de las levaduras seleccionadas para la fermentación.
Fermentación maloláctica
De igual manera, si nuestro producto debe realizar la fermentación maloláctica, nos ayudamos de las bacterias lácticas, las cuales se encargan de reducir el ácido málico, y con ello la acidez del vino, y cuya población también debemos tener controlada.
¿Quieres más información sobre el análisis enológico?
Posibles enfermedades organolépticas
Es en las etapas de crianza y envasado donde nos podemos encontrar con microorganismos no deseados, procedentes de la propia uva, de contaminaciones por limpieza insuficiente de los equipos o del propio ambiente de la bodega, que proliferan y encuentran las condiciones adecuadas para multiplicarse en el vino, pudiendo dar lugar a enfermedades y/o alteraciones organolépticas que afectan negativamente a la calidad de nuestro producto final.
Las enfermedades que pueden afectar al vino y sus derivados son variadas: picado acético, picado láctico, avinagrado, ahilado, olor a cuero, formación de moléculas y productos metabólicos nocivos que aportan olores indeseados… y pueden estar causadas por levaduras, bacterias y hongos.
Enfermedades provocadas por levaduras
En cuanto a las enfermedades provocadas por levaduras, podemos hablar de las llamadas “flores” del vino, donde por ejemplo algunas especies de los géneros Pichia y Hansenula forman un velo y se desarrollan reduciendo el extracto seco del vino y también de las refermentaciones en condiciones de anaerobiosis. Otra de las alteraciones comunes en el vino es la producida por levaduras del género Brettanomyces/Dekkera, que le otorgan al vino el denominado olor a “cuero”. Por último, están los mohos que pueden provocan inestabilidad organoléptica y biológica en el vino.
Enfermedades provocadas por bacterias
Por otro lado, si hablamos de las infecciones provocadas por bacterias, podemos encontrar las causadas por bacterias lácticas o acéticas.
- Las bacterias lácticas pueden fermentar los azúcares y dar lugar a la formación de ácido acético, ácido láctico… provocando un aumento de la acidez fija y la volátil. Pero también pueden dar lugar a las enfermedades del ahilado y del amargor.
- Las bacterias acéticas provocan la enfermedad más corriente y que más daños provoca en el vino, el avinagramiento o picado acético, donde aparece un aumento de la acidez volátil del vino y puede darse la formación de acetato de etilo.
Algunos de estos microorganismos pueden ser beneficiosos para desarrollar derivados del vino, como es el caso de las bacterias acéticas y el vinagre, o para obtener metabolitos usados en otros tipos de industria como la cosmética.
>También te puede interesar: Análisis de pesticidas en el vino: límites legales
En cualquier caso, el minucioso control microbiológico de nuestro producto, en las diferentes etapas de su desarrollo, nos llevará a obtener un producto final de calidad, estable química, biológica y físicamente, y que perdure una vez embotellado para que el consumidor pueda disfrutar de él y de sus peculiares y exclusivas características pasado el tiempo.